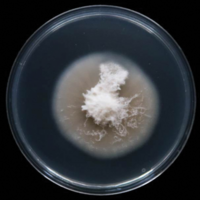
Four new species of Microdochium (Microdochiaceae, Xylariales

myco Four new species of Microdochium (Microdochiaceae, Xylariales
(2968件)
Pontaパス特典
サンキュー配送
9367円(税込)
94ポイント(1%)
Pontaパス会員ならさらに+1%ポイント還元!
送料
(
)
2964
配送情報
お届け予定日:2026.05.05 0:48までにお届け
※一部地域・離島につきましては、表示のお届け予定日期間内にお届けできない場合があります。
ロットナンバー
60986127654
お買い物の前にチェック!

Pontaパス会員なら
ポイント+1%
ポイント+1%
商品説明




















◉北欧スタイル◉ インダストリアルデザイン◉GARTガルトチェアカウンターチェアハイスツールスツールスチール脚モダン椅子完成品北欧スタイルのハイスツール。ゴールド×ブラックカラーのシックでシンプルかつクールな存在感あるインダストリアルデザイン。⚫︎コンディション⚫︎目立つような汚れやキズなどなく、全体的に非常に良い状態と思います。非喫煙、ペット飼育なしの環境下での保管です。※出来る限り実物のお色味に近くなるよう撮影していますが、お使いの端末や環境により若干異なって見える場合があります。⚫︎定価⚫︎ (廃盤・完売)36300円⚫︎サイズ⚫︎全体:約 幅53×奥行47×高さ77 (cm)座面クッション:約 1辺41.5×厚み3 (cm)座面の厚み(木部含む):約 6.5 (cm)座面の高さ:約 46〜60 (cm)足置きの高さ:約 31.5 (cm)脚:約 幅3〜4.5××長さ71.5 (cm)脚同士の間隔(最下部):約46.5 (cm)⚫︎重さ⚫︎約5.5kg⚫︎耐荷重⚫︎約90kg⚫︎材質⚫︎座面:ポリウレタン\r木部:アッシュ材\r足掛け:スチール(ブロンズメッキ塗装)⚫︎カラー⚫︎木部:ブラック座面:ブラック足置き:ゴールド(艶消し)⚫︎配送について⚫︎緩衝材でお包みし、段ボールで補強してお届け致します。★その他の照明•家具→#スライトエッジ家具935250809-051002250818-n047S832r
| カテゴリー: | 家具・インテリア>>>椅子・チェア>>>スツール |
|---|---|
| 商品の状態: | 目立った傷や汚れなし","細かな使用感・傷・汚れはあるが、目立たない |
| ブランド: | GART |
| 配送料の負担: | 送料込み(出品者負担) |
| 配送の方法: | 佐川急便/日本郵便 |
| 発送元の地域: | 福岡県 |
| 発送までの日数: | 1~2日で発送 |
レビュー
商品の評価:




 4.6点(2968件)
4.6点(2968件)
- ジャーミー
- 6ヶ月の甥にプレゼントとしました、甥よりも、まだ大きいスツールですが 興味深々です、
- てーちゃん04
- 恐竜とブタを購入(象は売り切れになったので)しました。肌触りも良くて何より可愛いです。ただ、もしかしてと思っていたらやっぱりブタさんに目玉がついていませんでした。目玉はある方が可愛いと思うので、何かつけようと思います。まだ出していないので、子どもたちは見ていませんが、使うときが楽しみです。
- shigezou36
- フローリングにカーペット敷きたくないけど、ソファは狭くて置けないし、座布団やクッションも嫌だなって思ってたら見つけました。 しっかりしてるけど、固くなくていい感じです。色合いもオークホワイトの家具たちとマッチしてると思います。
- ちびちゃん4696
- 先日間違えてプードルを買ってしまいましたが、子どもたちから、どうしてもトイプードルもほしいというリクエストがあり購入しました。二匹並んで、部屋が賑やかになりました。 2-3 j0-0025 希望です。よろしくお願い致します。
- torihito
- 人気があるのが分かりますね!とてもいい商品。何台も欲しくなる!
- くもりあめ38
- トイプードルを買うつもりが、間違えてプードルを買ってしまいました。交換していただこうか迷いましたが、よく見ると羊みたいに可愛いので使うことにしました。 12-3 j0-0005 希望です。よろしくお願いします。
- nanathuboshi
- 品があり言うことが無いぐらいとても良い商品です。スツールで高さ変更できるのがありがたいです。後ろからも座れるのでとても使い勝手が良いです !少し安い時に買えたのも良かったです!とても大事に致します。ありがとうございました。
- モエハル2305
- ベビーベッドでのお世話の際に使用しています。 キリンさんにしましたが、子供が顔を触って楽しそうに遊んでいます。 足カバーがはずれやすいですが、大人が座っても大丈夫なので買って良かったです。
すべて見る
お店の情報
7,367
連絡・応対
4.3
配送スピード
4.3
梱包
4.3